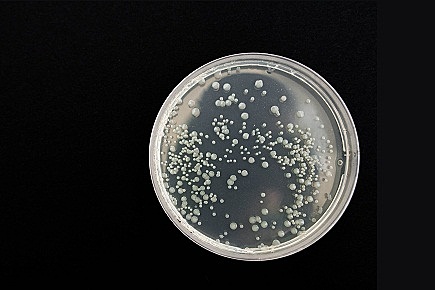
Fulius Richard Petri

-
Inventor del microscopio compuesto.
-
Este libro contiene por primera vez la palabra célula.
-
Los gusanos se desarrollaban espontáneamente
-
Descubrió los microorganismos a los que llamó “animalucos”
-
Publica dibujos de bacterias
-
Sentó las bases de la taxonomía moderna, creando un sistema de nomenclatura binomial para clasificar a los seres vivos
-
Descubrió la vacuna de la viruela. Desarrolla técnicas de vacunación
-
Primera vacunación contra la viruela
-
Levadura que aparece por la fermentación alcohólica era una planta microscópica
-
Demostró la gran barrera entre los reinos animal y vegetal. Acuñó el término “metabolismo”
-
primer estudio epidemiologico del cólera
-
Relación entre los microorganismos en infusiones orgánicas y los cambios químicos
-
Precursor de la división entre los seres procariotas y eucariotas.
-
Evidenció la existencia de formas microbianas por reposo, muy resistentes al calor.
-
Surgimiento del agar como una sustancia ideal para medio de cultivo
-
Descubrió el proceso biológico de la ntrificación
-
Desarrolla método de tinción de bacterias, utilizando lugol y etanol, esto permitió dividir las bacterias en Gram-positivas y en Gram-negativas ya que unas se teñían y otras no, clasificación que es de gran utilidad para elegir un tratamiento antibiótico.
-
Inventó la plata petri para el cultivo de microorganismos.
-
confirman que la fiebre amarilla es transmitida por mosquitos
-
Descubrió el primer antibiótico, penicilina
-
Inventa el microscopio electrónico
-
Descubren que el DNA es material genético, ya que anteriormente se creía que eran proteínas las portadoras de los genes.
-
Descubrieron la estructura molecular del DNA.
-
Clasificación taxonómica de seres vivos en cinco reinos: Animal, Vegetal, Fungi, Protista y el actualmente reino Monera.
-
Especies de la llamada secuencia de ARN, lo llevaron al descubrimiento de un nuevo dominio, Archaea.
-
Descubrimiento del virus del sida
-
revelaron aspectos regulatorios que son clave
para comprender el ciclo de división celular -
Aparece en China la neumonía atípica (síndrome respiratorio agudo, SARS), enfermedad respiratoria producida por un coronavirus.
-
la bacteria Helicobacter pylori es la causante tanto de úlceras
estomacales como de gastritis -
Descubrimiento del virus del papiloma humano y el virus de la inmunodeficiencia adquirida
-
En México aparece un brote de gripe porcina, posteriormente llamada gripe A H1N1
Tipo A del virus de la gripe, perteneciente a la familia de los Orthomyxoviridae. -
hallazgo de una especie bacteriana, llamada Thiolava veneris, hasta ahora desconocida, asociada a la actividad volcánica del Tagoro
-
Proyecto Flamenco de la Flora Intestinal donde se Identificaron dos tipos de bacterias (Coprococcus y las Dialister) del intestino que están relacionados con la depresión
Looking for a timeline maker?
Create timelines for projects, roadmaps, history, lessons, legal cases, and stories with Timetoast. Timetoast is a timeline maker for work, school, research, and stories.